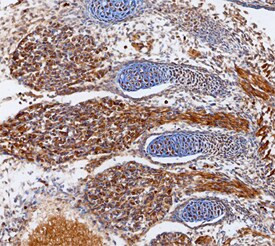
ADAMTS1 Antibody in Immunohistochemistry (Frozen) (IHC (F))

Search
Invitrogen
ADAMTS1 Polyclonal Antibody
{{$productOrderCtrl.translations['antibody.pdp.commerceCard.promotion.promotions']}}
{{$productOrderCtrl.translations['antibody.pdp.commerceCard.promotion.viewpromo']}}
{{$productOrderCtrl.translations['antibody.pdp.commerceCard.promotion.promocode']}}: {{promo.promoCode}} {{promo.promoTitle}} {{promo.promoDescription}}. {{$productOrderCtrl.translations['antibody.pdp.commerceCard.promotion.learnmore']}}
图: 1 / 2
ADAMTS1 Antibody (PA5-47790) in IHC (F)


Please note: We are reviewing Western blot images included in the antibody testing data in our catalog, including those provided by third parties. Unless expressly labeled or annotated as “raw-unedited”, Western blot images included in the antibody testing data in our catalog may have been edited, optimized or otherwise adjusted for presentation.
产品信息
PA5-47790
种属反应
已发表种属
宿主/亚型
分类
类型
抗原
偶联物
形式
浓度
规格
纯化类型
保存液
内含物
保存条件
运输条件
RRID
产品详细信息
In direct ELISAs, less than 5% cross-reactivity with recombinant human (rh) ADAMTS4 and rhADAMTS15 is observed and less than 1% cross-reactivity with rhADAMTSL1.2, rhADAMTSL2, rhADAMTS5, rhADAMTS8, rhADAMTS10, rhADAMTS12, rhADAMTS13, and rhADAMTS16 is observed.
Reconstitute at 0.2 mg/mL in sterile PBS.
靶标信息
ADAMTS-1 is a member of the ADAMTS (a disintegrin and metalloproteinase with thrombospondin motif) protein family. Members of the family share several distinct protein modules, including a propeptide region, a metalloproteinase domain, a disintegrin-like domain, and a thrombospondin type 1 (TS) motif. Individual members of this family differ in the number of C-terminal TS motifs, and some have unique C-terminal domains. The protein encoded by this gene contains two disintegrin loops and three C-terminal TS motifs and has anti-angiogenic activity. The expression of this gene may be associated with various inflammatory processes as well as development of cancer cachexia. This gene is likely to be necessary for normal growth, fertility, and organ morphology and function.
仅用于科研。不用于诊断过程。未经明确授权不得转售。
生物信息学
蛋白别名: a disintegrin and metalloproteinase; A disintegrin and metalloproteinase with thrombospondin motifs 1; a disintegrin-like and metalloprotease (reprolysin type) with thrombospondin type 1 motif, 1; ADAM; ADAM-TS 1; ADAMs; metalloendopeptidases; METH-1
基因别名: ADAM-TS1; ADAMTS; ADAMTS-1; ADAMTS1; C3-C5; KIAA1346; METH-1; METH1
UniProt ID: (Mouse) E9QMN9
Entrez Gene ID: (Mouse) 11504